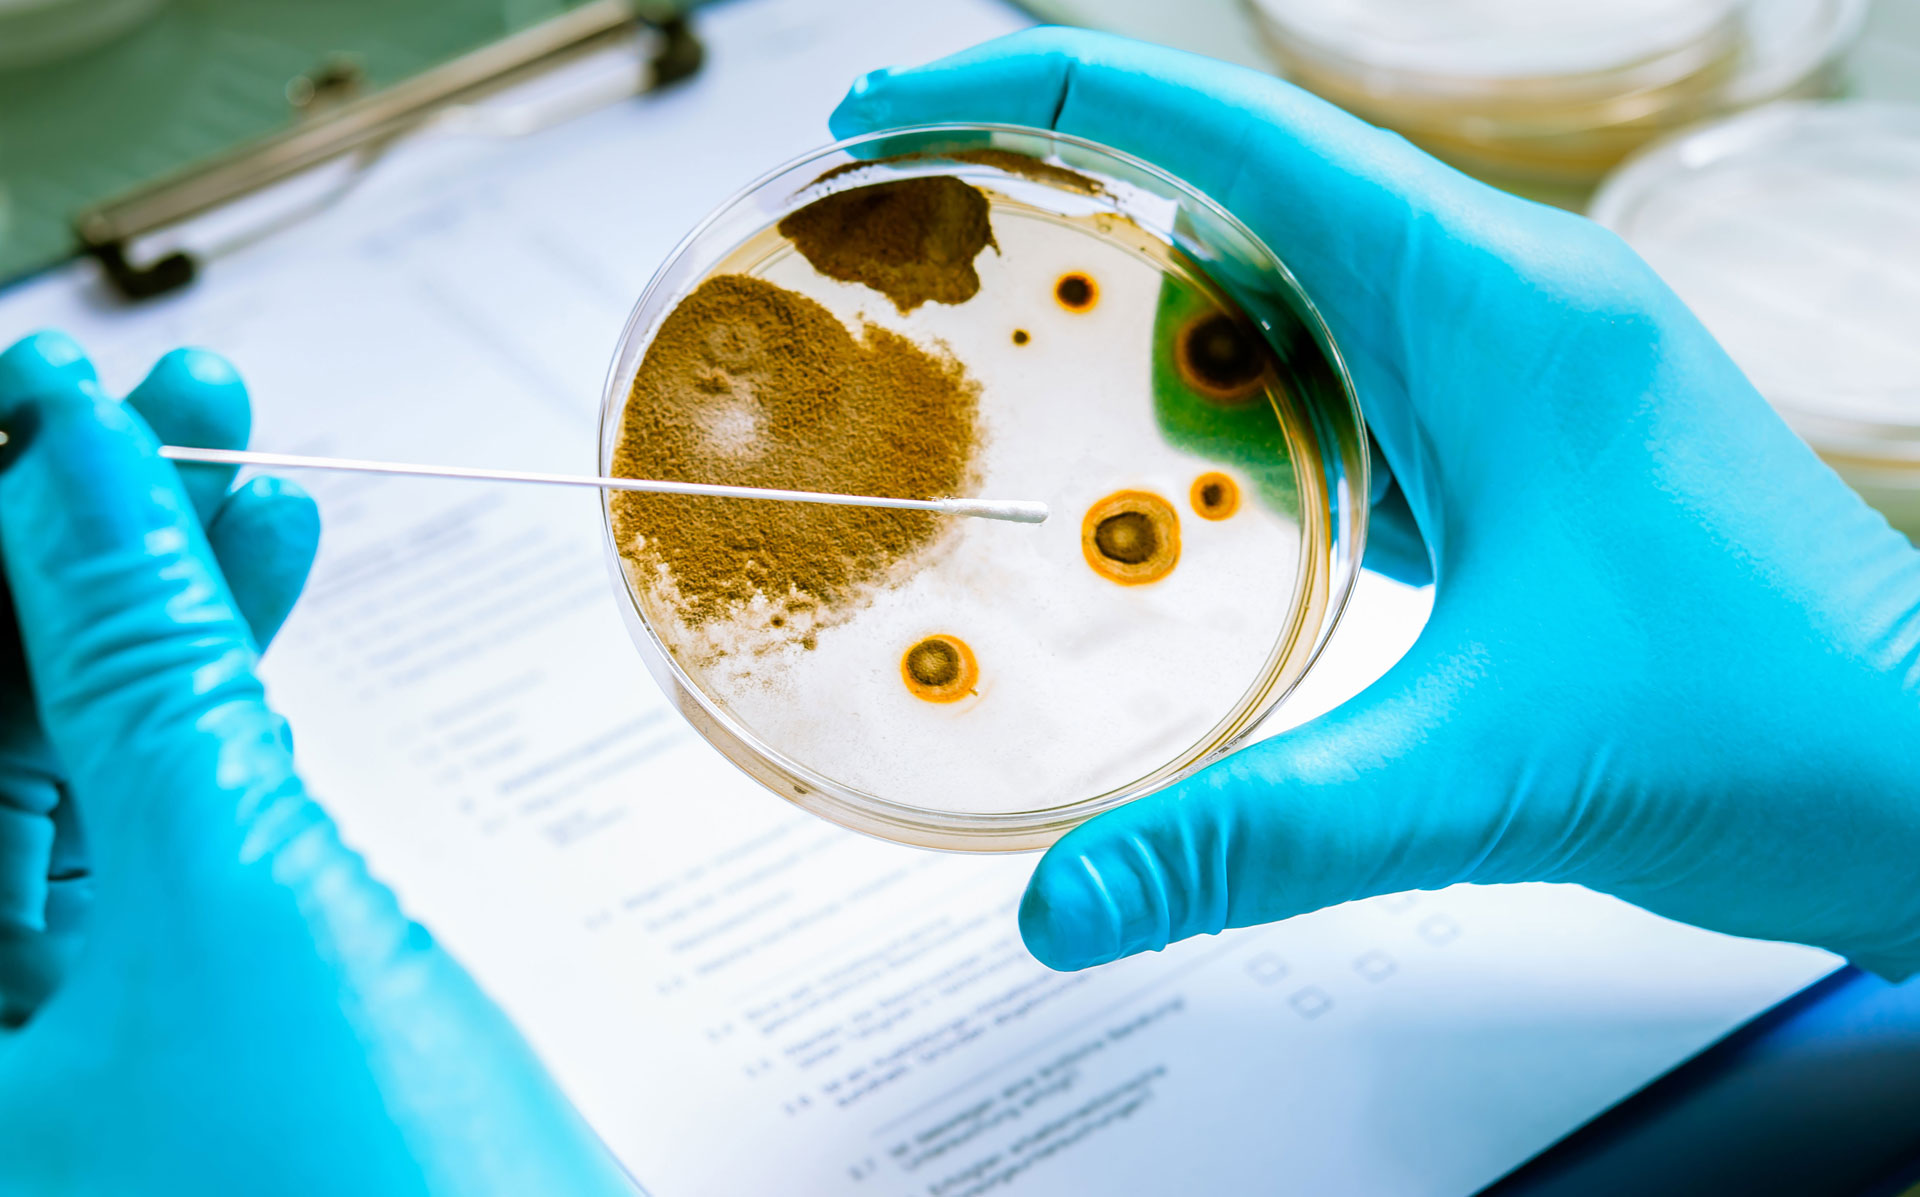
Mykologie - Spezielle Untersuchungen zum Nachweis von Pilzinfektionen

Infektionsdiagnostik
Laborleistungen im Überblick
Unter einer "Infektion" ist das aktive oder passive Eindringen und die anschließende Vermehrung von Krankheitserregern im Körper zu verstehen. Diese Krankheitserreger können Bakterien, Viren, Pilze oder Parasiten sein. Sie können eine Abwehrreaktion des Immunsystems auslösen, die zur Bildung spezifischer Antikörper oder Abwehrzellen führt. Der Nachweis einer Infektion kann entweder durch einen direkten Erreger-Nachweis (Bakterienanzucht, PCR, Antigen-Nachweis) oder indirekt über die induzierte Immunantwort des Körpers nachgewiesen werden (Antikörper-Nachweis, Zellfunktionsteste).
Bakteriologie
Als bakteriologische Untersuchung bezeichnet man den Nachweis, die Identifizierung und ggf. Quantifizierung von bakteriellen Krankheitserregern aus verschiedenen Proben.
Mykologie
Bei der medizinischen Mykologie handelt es sich um Untersuchungen zum Nachweis von durch Pilze hervorgerufene Infektionen. Für die gezielte Therapie kann für Hefepilze ein Antimykogramm oder ergänzend bei bestimmten Infektionen (Hautinfektionen,…
Parasitologie
Bei der medizinischen Parasitologie handelt es sich um immunologische oder mikroskopische Untersuchungen zum direkten Nachweis parasitärer Krankheitserreger. Die meisten Parasiten können dadurch untersucht werden:
Virologie
Bei der medizinischen Virologie handelt es sich vornehmlich um infektionsserologische oder molekularbiologische Untersuchungen (PCR) zum direkten oder indirekten Nachweis viraler Krankheitserreger. Hierbei können die meisten viralen Erkrankungen…
Sexuell übertragbare Erkrankungen
Infektionen mit Chlamydia trachomatis gehören zu den weltweit am häufigsten sexuell übertragbaren Erkrankungen. Die Infektionen erfolgen häufig bereits im jungen Erwachsenenalter und bleiben in der Regel unbemerkt, da urogenitale…
SARS-CoV-2-Diagnostik
Umfassendes Analysenspektrum
Im Bereich der SARS-CoV-2-Diagnostik steht ein umfangreiches Leistungsspektrum zur Verfügung -mit folgenden Testoptionen.